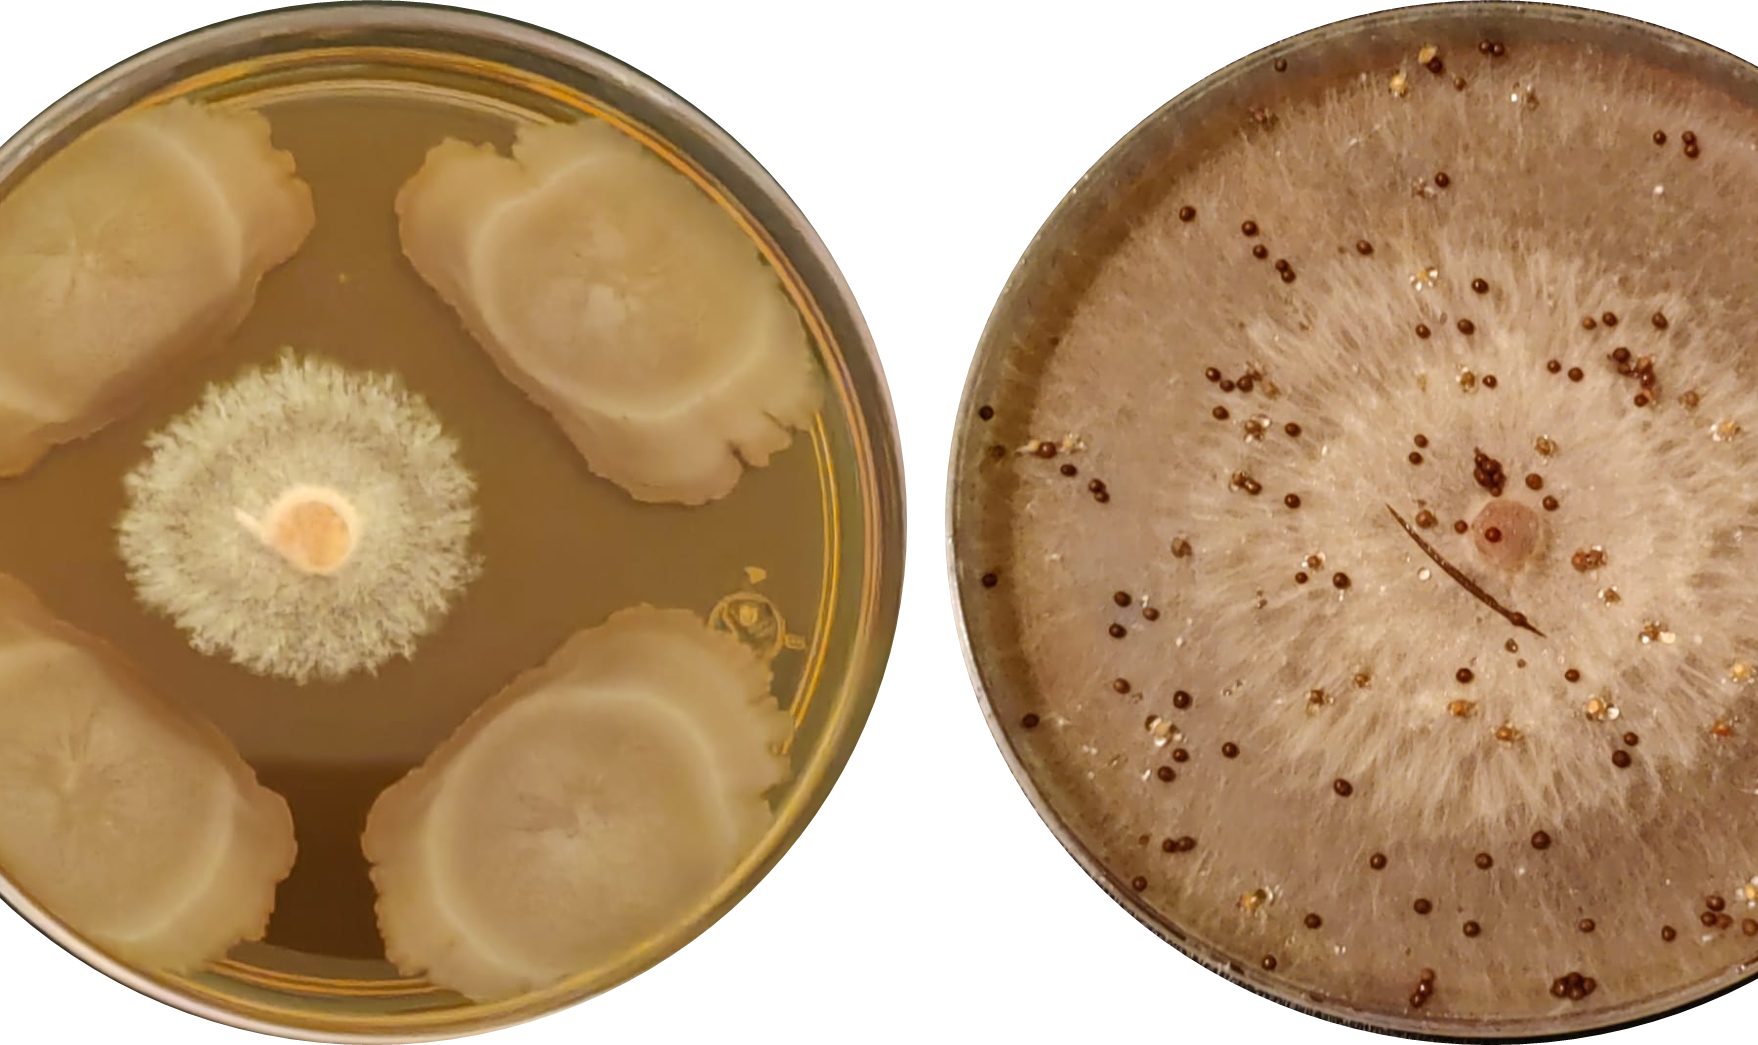

VII Congreso Virtual Internacional Abanico Veterinario, Agroforestal, Ambiental, Pesquero, Acuícola y del Mar, 2026.
VII Congreso Virtual Internacional Abanico Veterinario, Agroforestal, Ambiental, Pesquero, Acuícola y del Mar, 2026. Es virtual asincrónico todo el año. Se participa con el escrito y video. Se publica memoria del congreso, video en Abanico Canal y libro. Se entrega Constancia de ponentes en congreso y Constancia del video publicado.
Leer más acerca de VII Congreso Virtual Internacional Abanico Veterinario, Agroforestal, Ambiental, Pesquero, Acuícola y del Mar, 2026.